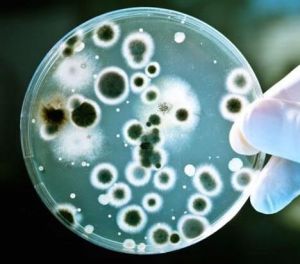
超超級細菌 超超級細菌

簡介
超超級細菌2015年底,華農國家獸醫微生物耐藥性風險評估實驗室則在中國境內的動物和人醫臨床菌株中發現了粘菌素耐藥基因mcr-1。
“超超級細菌”則是前兩類“超級細菌”耐藥基因的雜合和重組。
特點
“超超級細菌”是一種“泛耐藥細菌”,即細菌對常用抗菌藥物幾乎全部耐藥,而並非“全耐藥細菌”。就目前(2016年)情況來看,利用常規治療手段對付“超超級細菌”已沒了效果,因而,科學家對非常規治療手段則給予期望。
發現意義
華南農大劉雅紅教授團隊通過進一步的分子生物學研究發現,在分離出的這株大腸桿菌中不僅同時攜帶blaNDM-5和mcr-1兩個耐藥基因,且兩個基因同時位於一個可接合轉移的雜合質粒中。基於此,研究團隊提出了雜合質粒形成的模型。這種雜合的方式尚屬首次發現,為後續進一步研究相似的雜合質粒提供了可行的範本。